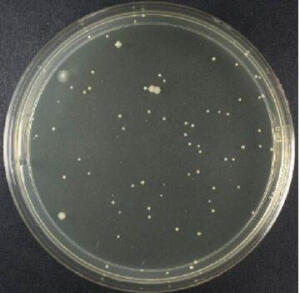

- 东莞市中草药检测单位,党参检测报告公司暂无价格广东顺德生食水产品高风险项目检测暂无价格佛山市枸杞检测、枸杞农药残留检测暂无价格佛山市食品接触材料检测认证,联系方式暂无价格肇庆市食品接触材料检测,联系方式暂无价格食品接触材料检测暂无价格农残检测蔬菜水果报告暂无价格瘦肉精检测暂无价格微生物检测暂无价格
- 清远市枸杞子检测报告公司,中草药检测单位暂无价格惠州市中草药检测单位,陈皮检测报告公司暂无价格黄芪检测报告,佛山市中草药检测单位暂无价格佛山市农药和肥料检测单位暂无价格广东广州食品接触材料测试服务,联系方式暂无价格佛山市食品及中药材重金属检测,联系电话暂无价格佛山市食品接触材料测试,新国标要求检测暂无价格广东佛山蔬菜水果农药残留检测暂无价格酒类产品检测暂无价格食品接触材料测试暂无价格食品毒害物质检测暂无价格黄曲霉毒素检测暂无价格